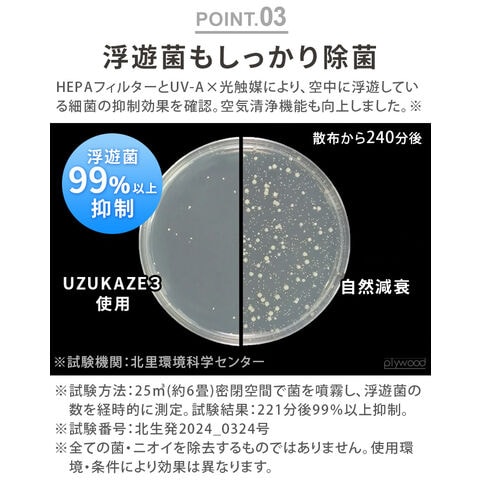

5/25
時点_ポイント最大13倍
Slimac UZUKAZE3 LEDファンシーリングライト ウズカゼ ≪ホワイト FCE-570WH≫ matter対応 シーリングファンライト 薄型 空気清浄機能 脱臭 除菌 照明 おしゃれ 軽量 リモコン付 サーキュレーター 羽なし 天井照明 調光調色
選択
-
ホワイト
販売価格
29,700
円 (税込)
送料込み
- 出荷目安:
- 1-5日以内に発送予定(店舗休業日を除く)
たまるdポイント(通常) 270
+キャンペーンポイント(期間・用途限定) 最大12倍
※たまるdポイントはポイント支払を除く商品代金(税抜)の1%です。
※表示倍率は各キャンペーンの適用条件を全て満たした場合の最大倍率です。
各キャンペーンの適用状況によっては、ポイントの進呈数・付与倍率が最大倍率より少なくなる場合がございます。
dカードでお支払ならポイント3倍
各キャンペーンの適用状況によっては、ポイントの進呈数・付与倍率が最大倍率より少なくなる場合がございます。
- 商品情報
- レビュー

|
|
| ブランド |
| Slimac / スライマック |
| サイズ |
| (約)幅53×奥行53×高さ10cm (スポンジ含む高さ:15cm) |
| 重 量 |
| 約3.7kg |
| 素 材 |
| 樹脂・アルミ・スチール |
| 消費電力(最大) |
| 最大58W |
| 器具光束 |
| 5500lm |
| 定格寿命 |
| 40,000h |
| 調 光 |
| 10段階 |
| 調 色 |
| 20段階 |
| 色温度 |
| 3000K - 6500K |
| Ra |
| 80 |
| 消費効率 |
| 131lm/w |
| 付属品 |
| リモコン×1、テスト用単4乾電池×2 |
| 備 考 |
| 空気循環機能 小型ファン3か所付 6段階の風量調整機能 おやすみモード、弱モード、中モード、やや強モード、強モード、最大モード 上部3ヶ所にHEPAフィルターを搭載 UV-A と光触媒による除菌・脱臭機能 スマートホーム共通規格matter対応 スマートスピーカー操作対応※Amazon Echo / Amazon Alexa / Google Home / Home Pod タイマー機能付き |
| ご注意 |
| 全ての菌・ニオイを除去するものではありません。使用環境・条件により効果は異なります。 本器具は、室内の空気を除菌・脱臭することを目的としております。屋外での使用・目的外のご使用はおやめください。 UV-Aの光は人体に有害であり、皮膚の炎症や目の痛みを引き起こす原因となります。光を直視したり光を直接浴びないよう取扱説明書に沿って適切にご使用ください。 調光器(ライトコントロール)との併用は出来ません。 本製品をご使用中に、ラジオ等の音響機器への雑音や、他の家電製品の赤外線リモコンが作動しない場合がごくまれにあります。 スマホ等スマートホームが使える端末と無線LAN(Wi-Fi)環境を事前にご準備ください。 モバイル端末の操作の際は必ず2.4GHz帯(IEEE802.11b/g/n対応)のWi-Fi(無線LAN)に接続してください。(※5GHz帯ではご使用できません。) モバイル端末操作は脱臭・除菌機能、タイマー操作には対応していません。 バージョンアップ等で予告なく変更する場合があります。 説明書に記載があっても一部の機能もしくは全機能非対応になる場合もあります。詳しくは各スピーカーやスマホ、アプリの説明ページを確認ください。 スマートホームの操作は予告なく終了することがあります。 Androidは現在、スマートスピーカー)なしでのMatterアクセサリ操作に対応していません。 ※2025年3月現在。 UZUKAZE専用アプリでは操作できません |
| 取付方法 |
| 天井引掛シーリング、埋込ローゼット この器具は天井取付専用器具です。天井が平らであることをお確かめください。下記のような天井に取り付けますと、器具がガタついたり、簡単に回転して取り付けが不十分となり、火災、感電、落下の原因となります。 【取付禁止天井】 船底天井・格子天井・竿縁天井・傾斜天井・その他に凸凹のある天井には取り付けないでください。 |
| お手入れについて |
| 2週間に1回程度フィルターの表面(黒い面)に付いたホコリを掃除機等で取ってください。 フィルターはカバーごと本体から取り外し可能。 フィルターは約1年程度で交換してください。 フィルターの裏面(白い面)はお手入れしないでください。 フィルターは傷が付きやすいため、強く押さないでください。水洗いはしないでください。 器具本体も1年に1度は定期点検をしてください。 |
| 仕様変更について |
| ※2025年4月にモデル変更しました。「Slimac UZUKAZE2 FCE-550」の後継モデルです。旧モデルとはデザインなど仕様が異なります。 【変更箇所】 ・本体のデザイン、サイズ、重量が変わりました。 ・脱臭、除菌機能が追加になりました。 ・matter対応になりました。(UZUKAZE専用アプリは不対応) ・パッケージデザイン変更。 |
| 保証期間 |
| お買い上げから1年 |
| パッケージ |
| 紙箱入り:(約)幅60×奥行16×高さ58cm 約4.6kg ※仕様は予告なく変更する場合があります。 |